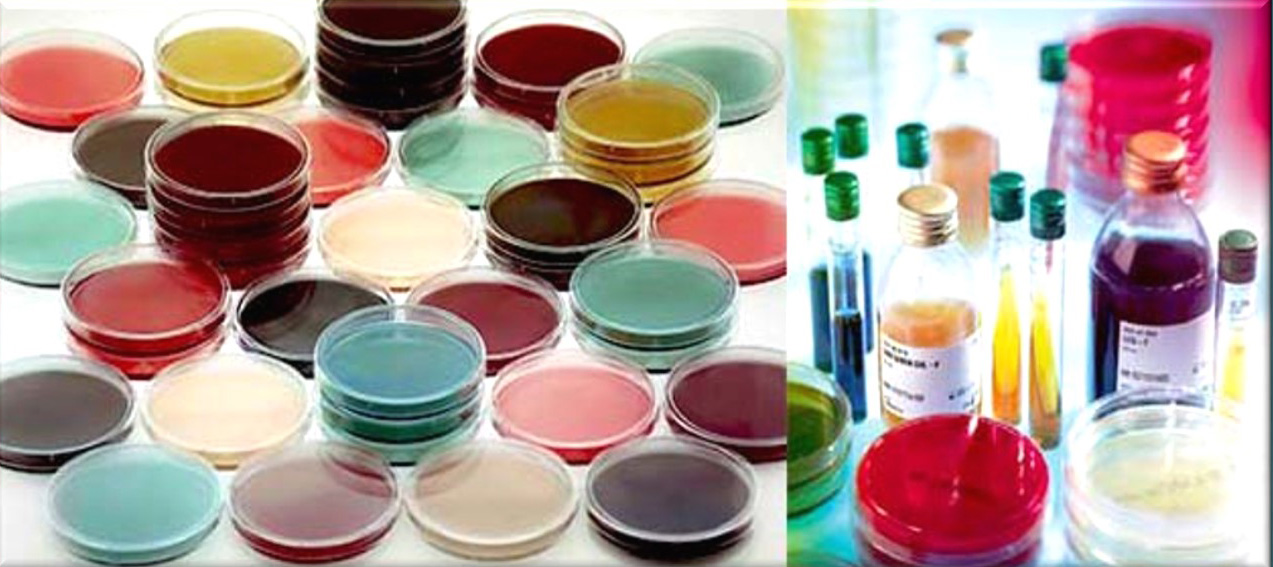

- Teacher: Blanco Ortiz Albert
- Teacher: Cañas Pacheco MARIA ALEXANDRA
- Teacher: Jaime Rodriguez Carolina
- Teacher: Merino Montero Susana
- Teacher: Nieto Marqueño José María
- Teacher: Ramos Barbero Loles
- Teacher: Rodriguez Rubio Lorena
Color de fons
Font Face
Font Kerning
Mida de la lletra
Visibilitat de la imatge
Espaiat de les lletres
Alçada de la línia
Ressaltat dels enllaços
Color del text